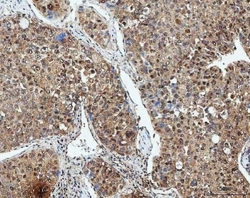

Antibody data
- Antibody Data
- Antigen structure
- References [0]
- Comments [0]
- Validations
- Western blot [2]
- Immunocytochemistry [2]
- Immunohistochemistry [5]
- Flow cytometry [1]
Submit
Validation data
Reference
Comment
Report error
- Product number
- RQ7495 - Provider product page

- Provider
- NSJ Bioreagents
- Product name
- SDE2 Antibody
- Antibody type
- Polyclonal
- Description
- This highly specific SDE2 antibody is suitable for use in Western blot/Immunofluorescence/Flow cytometry/Immunohistochemistry/Direct ELISA applications with human samples.
- Reactivity
- Human
- Host
- Rabbit
- Conjugate
- Unconjugated
- Vial size
- 100 ug
- Concentration
- 0.5mg/ml if reconstituted with 0.2ml sterile DI water
- Storage
- After reconstitution, the SDE2 antibody can be stored for up to one month at 4oC. For long-term, aliquot and store at -20oC. Avoid repeated freezing and thawing.
No comments: Submit comment
Supportive validation
- Submitted by
- NSJ Bioreagents (provider)
- Main image

- Experimental details
- Western blot testing of human 1) K562 and 2) U-251 cell lysate with SDE2 antibody. Predicted molecular weight ~50 kDa.
- Submitted by
- NSJ Bioreagents (provider)
- Main image

- Experimental details
- Western blot testing of human 1) K562, 2) HEL, 3) Jurkat and 4) ThP-1 cell lysate with SDE2 antibody. Predicted molecular weight ~50 kDa.
Supportive validation
- Submitted by
- NSJ Bioreagents (provider)
- Main image

- Experimental details
- Immunofluorescent staining of FFPE human U-2 OS cells with SDE2 antibody (red) and Alpha Tubulin mAb (green). HIER: steam section in pH6 citrate buffer for 20 min.
- Submitted by
- NSJ Bioreagents (provider)
- Main image

- Experimental details
- Immunofluorescent staining of FFPE human U-2 OS cells with SDE2 antibody (red). HIER: steam section in pH6 citrate buffer for 20 min.
Supportive validation
- Submitted by
- NSJ Bioreagents (provider)
- Main image

- Experimental details
- IHC staining of FFPE human esophageal squamous carcinoma tissue with SDE2 antibody. HIER: boil tissue sections in pH8 EDTA for 20 min and allow to cool before testing.
- Submitted by
- NSJ Bioreagents (provider)
- Main image
- Experimental details
- IHC staining of FFPE human liver cancer tissue with SDE2 antibody. HIER: boil tissue sections in pH8 EDTA for 20 min and allow to cool before testing.
- Submitted by
- NSJ Bioreagents (provider)
- Main image

- Experimental details
- IHC staining of FFPE human lung adenocarcinoma tissue with SDE2 antibody. HIER: boil tissue sections in pH8 EDTA for 20 min and allow to cool before testing.
- Submitted by
- NSJ Bioreagents (provider)
- Main image

- Experimental details
- IHC staining of FFPE human ovarian serous adenocarcinoma tissue with SDE2 antibody. HIER: boil tissue sections in pH8 EDTA for 20 min and allow to cool before testing.
- Submitted by
- NSJ Bioreagents (provider)
- Main image

- Experimental details
- IHC staining of FFPE human spleen tissue with SDE2 antibody. HIER: boil tissue sections in pH8 EDTA for 20 min and allow to cool before testing.
Supportive validation
- Submitted by
- NSJ Bioreagents (provider)
- Main image

- Experimental details
- Flow cytometry testing of fixed and permeabilized human Jurkat cells with SDE2 antibody at 1ug/million cells (blocked with goat sera); Red=cells alone, Green=isotype control, Blue= SDE2 antibody.